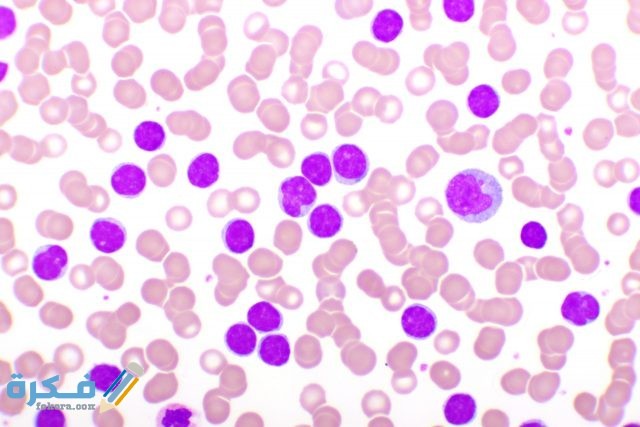
اسباب نقص خلايا الدم البيضاء اسباب نقص خلايا الدم البيضاء

عدد كريات الدم البيضاء 30000 وما هو سبب تغير المعدل الطبيعي لها في الجسم
صفاء حسن آخر تحديث :
عدد كريات الدم البيضاء 30000 وما هو سبب تغير المعدل الطبيعي لها في الجسم من خلال موقع فكرة كريات الدم البيضاء هي مجموعة من الخلايا التي تعمل كجزء من الجهاز المناعي للإنسان وتحميه من الإصابة بالأمراض .
عناصر المقال
ما هي كريات الدم البيضاء
- هي مجموعة من الخلايا التي يتم إنتاجها بواسطة النخاع العظمي للإنسان .
- تنتج كريات الدم البيضاء عند تمايز الخلايا الجذعية في النخاع ويتم إنتاجها بكميات محددة .
- تمثل كريات الدم البيضاء وسائل الدفاع الاساسية في جسم الانسان ضد الاجسام الغريبة من الفيروسات والبكتريا .
- أحد مكونات الجهاز المناعي لجسم الإنسان من الجلد وكريات الدم البيضاء والأجسام المضادة .

قد يهمك ايضًا : ماذا تشير نسبة الهيموجلوبين في الدم 9 ؟
النسب الطبيعية لكريات الدم البيضاء في الجسم
- تختلف عدد ونسب كريات الدم البيضاء في الجسم من سن إلى آخر .
- النسب الطبيعية لدى حديثي الولادة يتراوح بين 30000 حتى 9000 خلية .
- نسب كريات الدم البيضاء لدى الأطفال دون سن عامين تتراوح بين 17000 حتى 6200 خلية .
- عدد كريات الدم البيضاء لدى البالغين والأطفال فوق سن عامين من 5000 حتى 10000 خلية .
- أي زيادة أو نقص في تلك النسب تمثل خلل في إنتاج كريات الدم البيضاء يجب الكشف عنه وعلاجه .

مكونات خلايا الدم البيضاء
- الخلايا الليمفاوية وتمثل 20 -40 % من عدد الخلايا .
- خلايا حامضية وتمثل 1-4 % من نسب الخلايا الكلية .
- الخلايا المعادله او العدلات وتمثل النسبة الأكبر بنسبة 55-73 % من كمية الخلايا الكلية .
- خلايا وحيدة وتمثل 2-8 % من العدد الكلي لخلايا كرات الدم البيضاء .
- الخلايا القاعدية وهي أقل نسبة وتمثل 0.5 -1 % من عدد الخلايا الكلى .

قد يهمك ايضًا : هَلْ ارتفاع كريات الدم البيضاء خطير ؟ وما هي الأعراض المصاحبة له
اسباب نقص خلايا الدم البيضاء
- وجود مشكلات صحية في نخاع العظم المنتج لكريات الدم البيضاء .
- الاصابة بسرطان الدم او ما يعرف باسم نقي العظم وهو أخطر أسباب نقص كريات الدم البيضاء .
- الروماتويد والتهاب المفاصل ومرض الذئبة الحمراء وغيرها من أمراض المناعة الذاتية .
- أمراض المناعة المكتسبة مثل الإيدز أحد أسباب نقص كريات الدم البيضاء في الجسم .
- نقص حمض الفوليك وغيرها من الفيتامينات في الجسم بشكل حاد .
- ادمان الكحول لسنوات طويلة او شرب الكحول بكميات كبيرة .
- التغذية السيئة من الأسباب الرئيسية لنقص كريات الدم البيضاء نتيجة لنقص العناصر الأساسية المكونة لها .
- الإصابة باضطرابات في الطحال مثل الالتهابات وغيرها .
اسباب زيادة نسب كريات الدم البيضاء في الجسم
- القلق والتوتر المفرط يؤدي لزيادة نسب كريات الدم البيضاء في الجسم .
- ممارسة التمارين الرياضية بشكل زائد عن الحد ولفترة طويلة باستمرار .
- الحمل والمخاض من الأسباب الرئيسية لزيادة نسب الكريات البيضاء في الدم .
- الاصابة بالعدوى والالتهابات الخارجية في الفم والمعدة تؤدي لزيادة نسب الكريات البيضاء في الجسم .
- اضطرابات الجهاز المناعي يسبب زيادة نسب كريات الدم البيضاء .
- التدخين أحد أسباب زيادة كريات الدم البيضاء لحماية الجسم من أضرار التدخين قدر المستطاع .

قد يهمك ايضًا : ما أهمية الصفائح الدموية
أعراض وجود خلل في نسب كريات الدم البيضاء
- النقص الحاد في وزن الجسم بشكل سريع ومفاجئ .
- الحمى والارتفاع الحاد في درجات الحرارة .
- ظهور الخراجات الجلدية والتهابات الفم واللثة .
- الشعور بالتعب والإرهاق العام والإعياء بشكل مستمر .
- الاصابة بالعدوى بشكل متكرر ولفترات طويلة .
طرق إجراء فحص كريات الدم البيضاء
- يتم فحص نسب كريات الدم البيضاء من خلال فحص الدم الكامل .
- تؤخذ عينة من الدم من منطقة تجويف المرفق عن طريق الوخز .
- لا يحتاج تحليل الدم وكريات الدم البيضاء إلى الصوم إلا إذا تابعه تحاليل اخرى .
- يستطيع المريض العودة للنشاط اليومي العادي فور الانتهاء من إجراء التحليل .
- تتراوح النتائج الطبيعيه للفحص بين 4300 الى 10800 خلية من خلايا الدم البيضاء بشكل إجمالي .
- يوضح الفحص النسب المئوية لكل نوع من أنواع الخلايا المكونة لكريات الدم البيضاء .

الى هنا نصل الى نهاية مقال ” عدد كريات الدم البيضاء 30000 وأسباب تغير المعدل الطبيعي لها في الجسم” في حالة وجود استفسار يرجي ترك تعليق .
⚠️
تنبيه
هذه المعلومات لأغراض التوعية فقط ولا تغني عن استشارة الطبيب أو الصيدلي.
لا تتناول أي دواء بدون وصفة طبية من متخصص